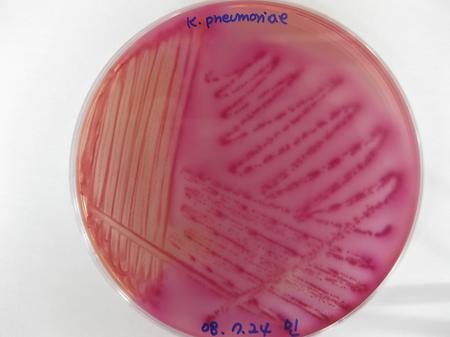
Klebsiella 1
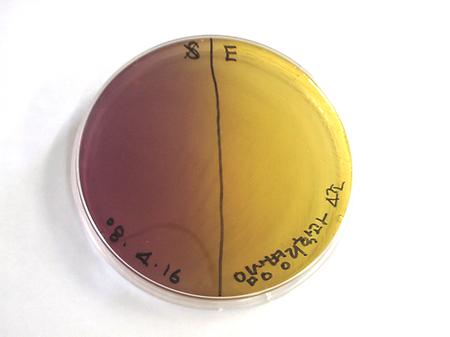
SF 배지 1

-
[2010년] 오리엔테이션2021-06-29 김영림 3931
-
[2008년] 자연과학대학 학술발표대회2021-06-28 김영림 4101
-
[2008년] 엠티2021-06-28 김영림 4311
-
[2008년] 체육대회2021-06-28 김영림 3930
-
[2008년] 스승의 날2021-06-28 김영림 3616
-
[2008년] 신입생 환영회2021-06-28 김영림 3563
-
[2008년] 예비대2021-06-28 김영림 3921
-
[2008년] 오리엔테이션2021-06-28 김영림 3607
-
[2008년] Klebsiella pneumoniae2021-06-28 김영림 3630
-
[2008년] TSI 접종 결과2021-06-28 김영림 3611
-
[2008년] MacConkey agar, EMB agar 접종 결과2021-06-28 김영림 5099
-
[2008년] SF 배지 접종 결과2021-06-28 김영림 4832